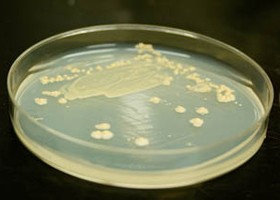
Botulizmus: tünetei, vizsgálata és kezelési lehetőségei

A botulizmus (a latin botulus, "kolbász" szóból) egy ritka, de veszélyes paralitikus (bénulásos) betegség.
A botulizmus a Clostridium botulinum Gram-pozitív, spórás, anaerob baktérium által okozott súlyos különleges formájú ételmérgezés. A spórákból kikelt kórokozó csak szigorúan oxigénmentes környezetben képes szaporodni, és magát a betegséget az általa termelt méreg (neurotoxin) okozza.
A botulinum toxin az egyik legerősebb ismert méreg
A bél fehérjebontó enzimei nem bontják. A szervezeten belül a vér útján terjed. Az étel okozta botulizmust olyan étel fogyasztása okozza, amely botulinum toxint tartalmaz. Sebbotulizmus sérülés során alakul ki, ilyenkor a seb Clostridium botulinum baktériummal fertőződik. Gyermekbotulizmust a baktérium spórájának elfogyasztása okozza, amely azután tenyészni kezd a belekben és toxint termel.
Botulizmus: tünetei, vizsgálata és kezelési lehetőségei
Forrás: EgészségKalauz
A botulizmus előfordulása
A baktériumok megtalálhatók a zöldségek levelén, talajban, állati bélcsatornában, természetes élőhelye mindenhol a föld, a trágya, friss és főzött mezőgazdasági termények. Mérgezés forrása általában a konzervek, szennyezett zöldségfélék, füstölt állati húsok, méz. Előidézhetik a nyersen elfogyasztott húsipari készítmények, de a lelkiismeretlenül, vagy rossz technológiával készült házi készítmények is.
A botulizmus okai
A baktérium által termelt méreg (toxin) neurotoxin, az acetilkolin felszabadulását gátolja, így testszerte jelentkeznek szimmetriás petyhüdt, bénulásos tünetek. A lefelé terjedő bénulás az agyidegekben kezdődik. A botulizmusnak mindig együttjáró tünetei az agyidegbénulások.
A botulizmus tünetei
18-36 órával az étel elfogyasztása után kezdődnek, de ez az idő lehet 2 óra vagy akár 8 nap is. Az ételbotulizmus esetek egyharmadában eleinte emésztőrendszeri tünetek, hányás, hasmenés jelentkezik.
Láz csak a seb-botulizmusban fordul elő, a lappangási idő ilyenkor 4-14 nap. Sebbotulizmus esetén nincsenek emésztőrendszeri tünetek.
- Eleinte étvágytalanság, nyáladzás, gyenge sírás, gyors izomkifáradás és a szemmozgató ideg bénulása mellett egész testre terjedő izomgyengeség észlelhető.
- Többnyire székrekedés (obstipáció) is fellép.
- Gyakori tünetek a homályos látás, kettőslátás, szemhéjcsüngés, szájszárazság, nyelési nehezítettség (dysphagia), légzési zavar. Az öntudat tiszta marad, de a beszédzavar (dysarthria), elkent beszéd miatt sokszor nehéz megítélni a beteget. A botulizmus előrehaladott stádiumában légzésbénulás és szívelégtelenség vezethet halálhoz.
A botulizmus lefolyása
Bármely életkorban előfordulhat. A betegség lefolyása széles határok között mozoghat: lehet enyhe, alig észrevehető, amikor csak a faciális(arc-, arcideg) bénulás észlelhető. Máskor nagyon gyors, halálos lehet a kimenetel légzési és keringési elégtelenség miatt. A beteg nem fertőző, elkülöníteni nem kell.
A botulizmus diagnózisa
Kóroki diagnózis a baktérium és toxin kimutatására székletből, hányadékból, a gyomormosó folyadékból, ételmaradékból. Elektromyographia (EMG), szemészeti és neurológiai vizsgálat a bénulások megítélésében játszanak fontos szerepet.
A botulizmus terápiája
Mivel a betegséget kizárólag a toxin okozza, nincs értelme antibiotikumot adni. A cél gyógyszeres kezeléssel az emésztőrendszerből még fel nem szívódott toxin eltávolítása; illetve a sejtekhez még nem kötődött méreg közömbösítése ellenszérummal.
A botulizmus megelőzése
A spórák a több órás főzést is kibírják, így képesek túlélni az élelmiszer-konzerválási technikákat. Maga a méreg (neurotoxin) hőérzékeny 80°C-on 5-10 perc alatt megsemmisül, így jól megfőzött, sütött ételekben nem kell mérgezéssel számolni.
A konyhai higiénés szabályok betartása, házilag készített konzervek, húsételek megfelelő, fogyasztás előtti forralása, hőkezelése.
Kolbászkészítésnél ügyelni kell a belek alapos átmosására és a földdel történő szennyeződés kizárására. Mivel a botulinum toxin - a legtöbb bakteriális toxinhoz hasonlóan - hőérzékeny, a betegség az ételek megfelelő hőkezelésével megelőzhető.
Élet a botulizmussal
Gyógytorna, neurológiai gondozás teljes rehabilitációt eredményez.
Egyéb tudnivalók a botulizmusról
A botulizmus, mint biológiai fegyver: az ENSZ ellenőrei már a 90-es évek közepén találtak Irakban olyan robbanófejeket, amelyek botulizmus-toxint tartalmaztak. Irak elismerte a toxin előállítását.
Hogyan kerül a toxin az élelmiszerekbe?
A Clostridium botulinum különleges körülmények között kezd toxintermelésbe: amikor az oxigén teljesen hiányzik, a pH 4,6 fölött van, és a hőmérséklet legalább 10–12 °C. Ezek az anaerob, meleg, enyhén lúgos közegben lévő körülmények főként házi konzervekben, olajos befőttekben, fóliázott húsokban, vagy rosszul lezárt, hűtés nélkül tárolt ételekben fordulnak elő.
Különösen kockázatosak:
- házi savanyúságok, amelyek nem elég savasak (pl. cékla vagy káposzta ecet nélkül),
- fokhagymás olajban eltett termékek (ahol a fokhagymán eredetileg jelen lehet a baktérium spórája),
- vákuumcsomagolt, nem hőkezelt füstölt halak,
- romlott húskészítmények.
A nem megfelelően sterilizált háztartási konzervkészítés során akár kis mennyiségű toxin is halálos lehet – ezért minden otthon készített étel esetén létfontosságú a hőkezelés és higiénia.
Miért olyan veszélyes a botulinum toxin?
A botulinum toxin blokkolja az ideg–izom közötti ingerületátvitelt azáltal, hogy megakadályozza az acetilkolin felszabadulását a motoros idegvégződésekben. Ez a mechanizmus teljesen lebénítja az izmokat, de nem jár fájdalommal vagy eszméletvesztéssel – ezért különösen alattomos. Az érintett személy sokszor teljesen tudatánál van, miközben a légzése leáll.
Az Egészségügyi Világszervezet (WHO) szerint már 1 nanogramm toxinnal is életveszélyes állapot idézhető elő testsúlykilogrammonként. Emiatt a botulinum toxin szerepel az egyik legveszélyesebb biológiai fegyverként nyilvántartott anyagok listáján is.
A csecsemők különösen veszélyeztetettek: miért nem ajánlott a méz?
A gyermekbotulizmus jellemzően 1 éves kor alatt fordul elő, különösen 2–6 hónapos csecsemőknél. Ilyenkor a baba lenyeli a baktérium spóráit (pl. méz vagy poros tárgy révén), majd azok a belekben szaporodni kezdenek, és toxin termelődik – ami a kicsi szervezetében bénulásos tüneteket okoz. Emiatt egyéves kor alatt szigorúan tilos mézet adni a csecsemőnek, még kis mennyiségben is.
A tünetek gyakran fokozatosan alakulnak ki:
- gyenge szopóreflex,
- csökkent mozgás,
- "puha" izomtónus,
- sírás gyengülése,
- székrekedés,
- légzési nehézség.
A diagnózishoz székletmintából kell kimutatni a baktériumot és toxinját.
Hogyan zajlik a diagnózis pontosabban?
A diagnózis főként klinikai tüneteken és a beteg kórtörténetén alapul (pl. házi készítésű étel fogyasztása után kialakuló neurológiai tünetek). Ezt követően laborvizsgálatokkal lehet megerősíteni:
- széklet, vér, gyomormosó folyadék vagy ételminta vizsgálata toxinelőállításra képes Clostridium botulinum jelenlétére,
- elektromiográfia (EMG) az izomingerület-válasz kimutatására,
- MRI vagy CT az egyéb neurológiai betegségek kizárása érdekében.
Az esetek egy részében az ellenszérum beadása megelőzi a laboreredmények beérkezését, mivel az időablak kritikus.
Hogyan működik az ellenszérum?
Az antitoxin (vagy ellenanyag) célja, hogy a keringésben lévő, még idegsejthez nem kötődött toxinokat semlegesítse. Ez azonban nem képes a már kötődött méreganyagot eltávolítani, így minél előbb kell beadni, lehetőleg az első 24 órán belül.
Az Egyesült Államokban és Európában főként kétféle ellenszérumot alkalmaznak:
- Polivalens botulinum antitoxin (7 típus ellen: A–G),
- Heptavalens (HBAT) ló eredetű antitoxin, amit súlyos esetekben alkalmaznak.
Mellékhatásként allergiás reakció is jelentkezhet, ezért a beadást kórházi környezetben végzik.
Hosszú távú következmények és rehabilitáció
Szerencsére a botulizmusban szenvedő betegek jelentős része – ha időben ellátást kap – teljesen felépülhet. A felépülés hónapokig is tarthat, és sokszor intenzív rehabilitációt igényel:
- légzőtorna,
- beszédterápia,
- gyógytorna az izomerő helyreállítására,
- pszichológiai támogatás a traumatikus élmények feldolgozásához.
A hosszú távú tünetek közé tartozhat:
- tartós fáradékonyság,
- enyhe légzési nehezítettség,
- koncentrációs zavarok,
- neuromuszkuláris gyengeség.
Egyes esetekben a teljes regeneráció több mint egy évet is igénybe vehet.
A botulinum toxin orvosi felhasználása: a kettős arc
Miközben a botulinum toxin életveszélyes lehet, kis dózisban orvosi célokra is alkalmazzák – főként idegi ingerületátvitel gátlására:
- Botox néven ismert kozmetikai célú felhasználás (ráncok csökkentése),
- spaszticitás kezelése (pl. agyi bénulásban),
- krónikus migrén, túlműködő hólyag, tikkelések, strabismus (kancsalság) esetén.
Az orvosi botulinum toxin szigorúan szabályozott környezetben, meghatározott indikációkra és dózisban történik – biztonságosan. A különbség tehát: a dózis és az alkalmazás módja.
Hogyan védekezhetünk a legjobban otthon?
A házi ételkészítés során a következő megelőző lépések különösen fontosak:
- Konzerválás előtt a zöldségeket alaposan mossa meg, és ha lehet, forralja legalább 10 percig.
- Ne használjon vákuumcsomagolást hőkezelés nélkül otthon készült húsokra vagy halakra.
- A füstölt kolbászt vagy hurkát sütés előtt forralja fel 10 percig, különösen, ha házilag készült.
- Ha a konzerv doboz puffadt, felpúposodott vagy sziszeg nyitáskor – azonnal dobja ki!
- Ne fogyasszon romlott szagú vagy furcsa ízű otthon készült ételt akkor sem, ha jól néz ki.
Mikor gyanakodjunk botulizmusra?
Bár a betegség ritka, az alábbi tünetek esetén érdemes gondolni rá:
- étkezést követő 12–48 órán belül jelentkező
- kettőslátás,
- szemhéjcsüngés,
- szájszárazság,
- nyelési nehézség,
- beszédzavar,
- légzési panaszok,
- különösen, ha házilag készített vagy gyanús ételt fogyasztott az illető.
Ilyen esetben azonnal orvoshoz kell fordulni – és a maradék ételmintát is célszerű megőrizni a kivizsgáláshoz.
Hazai vonatkozások – Magyarországon előforduló esetek
Magyarországon évente 1–5 botulizmus esetet regisztrálnak, melyek többsége házi kolbászhoz, húsféléhez köthető. 2004-ben például házi májas fogyasztása okozott több megbetegedést. Az Országos Epidemiológiai Központ figyelmeztetése szerint a téli disznóvágásos szezonban és a nyári melegben is nőhet a kockázat, ha nem megfelelő a hőkezelés és tárolás.
Kövesse az Egészségkalauz cikkeit a Google Hírek-ben, a Facebook-on, az Instagramon vagy a X-en,Tiktok-on is!









